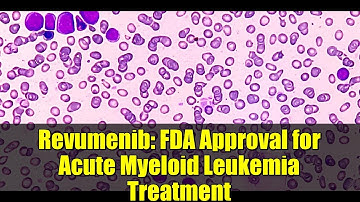
Revumenib: FDA Approval for Acute Myeloid Leukemia Treatment

⬇ DOWNLOAD NOW
Kalau muncul iklan pop-up, tutup lalu klik tombol kembali
Download lagu Toxicity prevention and management when using revumenib for the treatment of AML secara gratis hanya untuk keperluan promosi. Dukung artis favorit kamu dengan membeli musik original di iTunes atau platform resmi lainnya.
 Toxicity Management in the Treatment of R/R AML
Toxicity Management in the Treatment of R/R AML
 Key Lecture from the 2025 ASCO Annual and the EHA 2025 Congress — Acute Myeloid Leukemia
Key Lecture from the 2025 ASCO Annual and the EHA 2025 Congress — Acute Myeloid Leukemia
 Adverse events to look out for when treating AML with menin inhibitors
Adverse events to look out for when treating AML with menin inhibitors
 A Phase I trial of DSP-5336, a novel menin inhibitor, in the treatment of AML
A Phase I trial of DSP-5336, a novel menin inhibitor, in the treatment of AML
 The activity of revumenib in AML with NUP98 rearrangements
The activity of revumenib in AML with NUP98 rearrangements
 The safety and efficacy of revumenib in patients with KMT2A-rearranged or NPM1-mutated AML
The safety and efficacy of revumenib in patients with KMT2A-rearranged or NPM1-mutated AML
 The toxicity of induction therapy in AML
The toxicity of induction therapy in AML
Revumenib: FDA Approval for Acute Myeloid Leukemia Treatment
Revumenib: FDA Approval for Acute Myeloid Leukemia Treatment